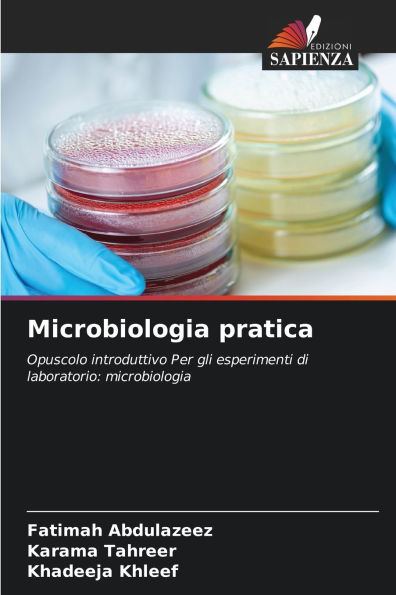
Microbiologia pratica

Home
L'educazione inclusiva nella pratica
Barnes and Noble
Loading Inventory...
L'educazione inclusiva nella pratica in Chattanooga, TN
Current price: $38.00

Barnes and Noble
L'educazione inclusiva nella pratica in Chattanooga, TN
Current price: $38.00
Loading Inventory...
Size: OS
Questo libro aiuterà i lettori e gli studiosi a realizzare l'educazione inclusiva. Con l'aiuto di questo libro, il concetto di educazione inclusiva cessa di essere un mito. Inoltre, porta alla luce i fattori che contribuiscono al raggiungimento dell'educazione inclusiva nelle scuole selezionate di Sogndal. Inoltre, questo libro è di grande utilità per coloro che studiano l'educazione speciale e per coloro che si occupano delle politiche del ministero dell'Istruzione in tutto il mondo.
Questo libro aiuterà i lettori e gli studiosi a realizzare l'educazione inclusiva. Con l'aiuto di questo libro, il concetto di educazione inclusiva cessa di essere un mito. Inoltre, porta alla luce i fattori che contribuiscono al raggiungimento dell'educazione inclusiva nelle scuole selezionate di Sogndal. Inoltre, questo libro è di grande utilità per coloro che studiano l'educazione speciale e per coloro che si occupano delle politiche del ministero dell'Istruzione in tutto il mondo.